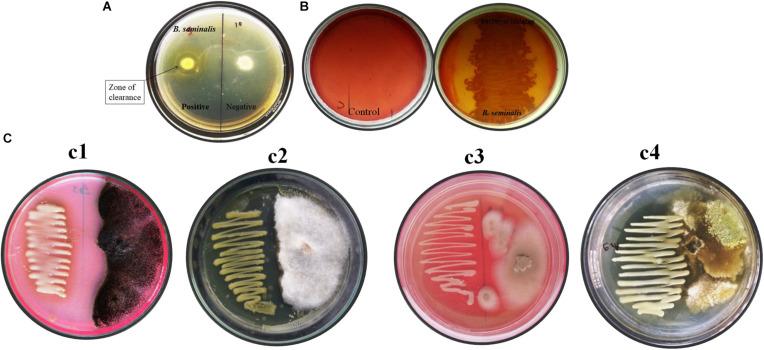
https://cdn.ncbi.nlm.nih.gov/pmc/blobs/8199/8079638/673543401cad/fmicb-12-633036-g001.jpg

干旱暴露的JRBHU6通过靶向多种细菌和真菌蛋白质的吡嗪-1,4-二酮衍生物展现出抗菌潜力。
Drought Exposed JRBHU6 Exhibits Antimicrobial Potential Through Pyrazine-1,4-Dione Derivatives Targeting Multiple Bacterial and Fungal Proteins.
作者信息
Prasad Jay Kishor, Pandey Priyanka, Anand Richa, Raghuwanshi Richa
机构信息
Department of Botany, Institute of Science, Banaras Hindu University, Varanasi, India.
Department of Chemistry, Institute of Science, Banaras Hindu University, Varanasi, India.
出版信息
Front Microbiol. 2021 Apr 14;12:633036. doi: 10.3389/fmicb.2021.633036. eCollection 2021.
The present study aimed to explore the antimicrobial potentials of soil bacteria and identify the bioactive compounds and their likely targets through studies. A total 53 bacterial isolates were screened for their antimicrobial potential of which the strain JRBHU6 showing highest antimicrobial activity was identified as (GenBank accession no. MK500868) based on 16S ribosomal RNA (rRNA) gene sequencing and phylogenetic analysis. JRBHU6 also produced hydrolytic enzymes chitinases and cellulase of significance in accrediting its antimicrobial nature. The bioactive metabolites produced by the isolate were extracted in different organic solvents among which methanolic extract showed best growth-suppressing activities toward multidrug resistant and fungal strains, , , , , and . The antimicrobial compounds were purified using silica gel thin layer chromatography and high-performance liquid chromatography (HPLC). On the basis of spectroscopic analysis, the bioactive metabolites were identified as pyrrolo(1,2-a)pyrazine-1,4-dione,hexahydro (PPDH) and pyrrolo(1,2-a)pyrazine-1,4-dione, hexahydro-3(2-methylpropyl) (PPDHMP). molecular docking studies showed the bioactive compounds targeting fungal and bacterial proteins, among which PPDHMP was multitargeting in nature as reported for the first time through this study.
本研究旨在探索土壤细菌的抗菌潜力,并通过研究确定生物活性化合物及其可能的靶点。共筛选了53株细菌分离株的抗菌潜力,其中表现出最高抗菌活性的菌株JRBHU6基于16S核糖体RNA(rRNA)基因测序和系统发育分析被鉴定为(GenBank登录号MK500868)。JRBHU6还产生了在证实其抗菌性质方面具有重要意义的水解酶几丁质酶和纤维素酶。该分离株产生的生物活性代谢产物在不同有机溶剂中提取,其中甲醇提取物对多药耐药菌和真菌菌株、、、、和表现出最佳的生长抑制活性。抗菌化合物通过硅胶薄层层析和高效液相色谱(HPLC)进行纯化。基于光谱分析,生物活性代谢产物被鉴定为吡咯并(1,2-a)吡嗪-1,4-二酮,六氢(PPDH)和吡咯并(1,2-a)吡嗪-1,4-二酮,六氢-3(2-甲基丙基)(PPDHMP)。分子对接研究表明生物活性化合物靶向真菌和细菌蛋白,其中PPDHMP具有多靶点性质,本研究首次报道。